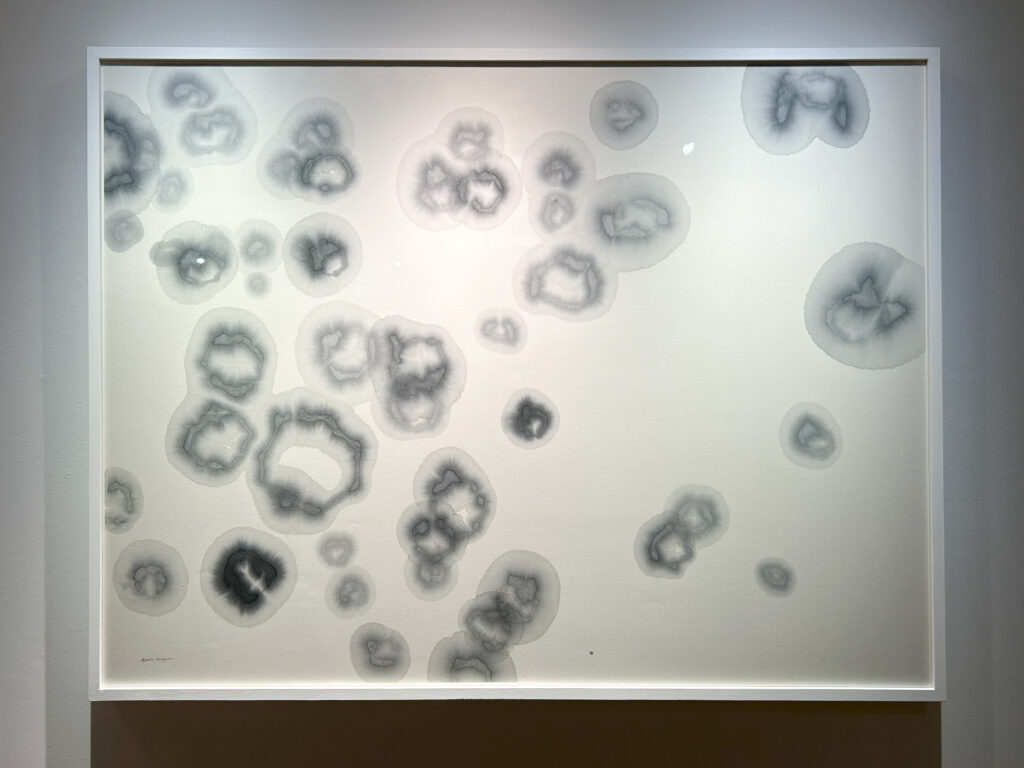

宮沢賢治の世界を、2人のアーティストが独自の創作スタイルや技法を駆使して可視化
AyakoSomeya+新里明士2人展 銀河の怜瓏
文、写真=ONBEAT編集部(一部オフィシャルサイト等参照)
コートヤードHIROOは、伝統的な技術に根ざしながらも現代的な視点によって作品を制作している陶芸家・新里明士と、書家Ayako Someyaによる「Ayako Someya+新里明士2人展:銀河の怜瓏」を2025年7月26日(土)~8月11日(月・祝)に開催する。本展は、「宇宙」をテーマとした視覚と味覚を通じた体験型の展覧会だ。
写真:ONBEAT編集部
「書」と「陶」という私たちに馴染みの深い伝統的な技法を用いながら、社会状況や普遍的(であると思われているよう)な事柄に対して問いを深める作品によって、現在、日本はもとより世界で注目を集めるAyako Someya(書)と新里明士(陶芸)の2人展を開催する。

写真:ONBEAT編集部
大気や鉱物の組成を化学記号(式)で書き表してきたSomeyaと、波動であり粒子である光を納める器を創ってきた新里は、「宇宙」をテーマとした新作を発表する。展覧会タイトルである「Ayako Someya+新里明士2人展:銀河の玲瓏」は、宮沢賢治(1896~1933年)による「青森挽歌」の一節である「きしや(注:汽車)は銀河系の玲瓏レンズ 巨きな水素のりんごのなかをかけてゐる」※1にインスパイアされたものだ。

写真:ONBEAT編集部
100年以上も前に自らが深く帰依する法華経に多大な影響を受けつつ、アインシュタイン(Albert Einstein, 1879~1955年)の学説を受容・理解した宇宙観(『銀河鉄道の夜』では、「これほど不完全な幻想第四次の銀河鉄道なんか、どこまででも行ける筈でさあ」※2と光速を超える銀河鉄道を表している)を持つ賢治の世界を、2人のアーティストが独自の創作スタイルや技法を駆使して如何に可視化・作品化するのか期待が高まる。

写真:ONBEAT編集部
気鋭の哲学者であるユク・ホイ(Yuk Hui, 生年不詳)は、その著書『中国における技術への問い 宇宙技芸試論』(2016年)の中で、「ギリシア的な技術をあらゆる技術の起源と考えてしまうなら、それは完全な方向の喪失/東洋の消失だといえる-そして不幸なことに、これこそいま起こっていることにほかならない」※3と述べている。Someyaと新里の邂逅によるケミストリー(化学反応)が紡ぐ、多様な宇宙(史)観が照応する展示空間をお見逃しなく。
※1:「青森挽歌」引用元:『【新】校本 宮澤賢治全集』第二巻 詩[1]、筑摩書房、1995年、156ページ
※2:『【新】校本 宮澤賢治全集』第十一巻 童話[4]、筑摩書房、1996年、150ページ ちなみに、アインシュタインは特殊相対性理論(1905年発表)で、光速は普遍的な速度であり、いずれ の慣性系から見ても一定であり、質量を有する物体が光速まで加速するためには無限のエネルギーを必要とするため、光速を超えることは不可能であると説いています。
※3:ユク・ホイ『中国における技術への問い 宇宙技芸試論』伊勢康平訳、ゲンロン、2022年、14ページ
ONBEATが注目するポイント
■伝統と革新の融合
新里明士氏の「光器」: 蛍手という技法を、独自の「光器」へと昇華させている点に注目。伝統技術を継承しつつ、現代的な感覚で新しい表現を生み出す姿勢は、どのような試行錯誤を経てこの作風にたどり着いたのか、その背景にある哲学や美意識について深く掘り下げて鑑賞するのもおもしろい。
Ayako Someya氏の書: 書という伝統的な表現方法を用いながら、大気や鉱物の組成を化学記号で表現するというアプローチは非常に革新的だ。古典的な書の技術と、科学的なモチーフという異質な要素がどのようにして一つの作品として調和しているのか。そのインスピレーションの源泉を探ることで、新しい書の可能性を感じることができる。
■ジャンルを超えた共鳴
新里氏の立体的な「光」と、Someya氏の二次元的な「文字・記号」。この二つが同じ空間に置かれることで、互いの作品が干渉し合い、一つのインスタレーションとして「銀河の怜瓏」という詩的な宇宙観を立ち上げている。「怜瓏(れいろう)」という言葉が持つ「冴え冴えと光り輝くさま」を、二つの異なる表現が一体となって体現している。

写真:オフィシャル引用
開催概要
銀河の怜瓏
会期:2025年7月26日(土)~8月11日(月・祝)
営業時間:12:00~19:00
休日:最終日の祝日を除く、月曜日は休廊
主催:株式会社アトム
企画:宮津大輔
コキュレーション:丹原健翔 & 宮津大輔
協力:東京画廊+BTAP、Yutaka Kikutake Gallery、ADIATE株式会社
公式サイト:https://cy-hiroo.jp/gallery/ginganoreirou/
展覧会を記念したスペシャルコラボレーションとして、Ayako Someyaが手掛けたオリジナル・ラベルの国産プレミアム・ウォッカ「KEYS&BRICKS」と、新里明士による特製の酒杯をセットにして販売する。

写真:オフィシャル引用 |

写真:オフィシャル引用 |

